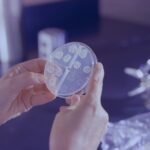
a person holding a round object in their hands

Beschreibung
Das primäre Parkinson-Syndrom ohne oder mit minimaler Beeinträchtigung bezieht sich auf das Frühstadium der Parkinson-Krankheit, in dem die Symptome mild sind und die täglichen Aktivitäten nicht wesentlich beeinträchtigen. Es entspricht den Hoehn- und Yahr-Stadien 0 bis unter 3, in denen motorische Symptome wie Ruhetremor, Bradykinesie (verlangsamte Bewegung), Muskelsteifheit und leichte Haltungsinstabilität auftreten können, aber beherrschbar bleiben. Die Symptome beginnen in der Regel einseitig und können sich über Jahre hinweg verschlechtern.
Die Parkinson-Krankheit ist die zweithäufigste neurodegenerative Erkrankung und betrifft etwa 1–2 % der über 65-Jährigen. Die Krankheit wurde erstmals 1817 von James Parkinson beschrieben und wird heute aufgrund verbesserter Screening-Verfahren häufiger im Frühstadium erkannt. Obwohl sie in erster Linie ältere Erwachsene betrifft, können Fälle mit frühem Ausbruch auch vor dem 50. Lebensjahr auftreten.
In diesem Stadium sind die Komplikationen minimal, können aber leichte motorische Schwierigkeiten, leichtes Zittern und gelegentliche Steifheit umfassen. Einige Patienten leiden unter leichter Müdigkeit, Schlafstörungen oder Stimmungsschwankungen, obwohl die kognitiven Funktionen weitgehend intakt bleiben. Ohne Intervention können sich die Symptome mit der Zeit verschlimmern und zu einer erhöhten Behinderung führen.
Die Diagnose erfolgt klinisch, basierend auf der Krankengeschichte und der neurologischen Untersuchung. Bildgebende Verfahren wie DaTscan und MRT helfen, andere Erkrankungen auszuschließen. Die Behandlung konzentriert sich auf die Symptomkontrolle, wobei die Medikation oft erst bei Bedarf eingesetzt wird. Physiotherapie, Bewegung und eine Änderung des Lebensstils sind der Schlüssel zur Aufrechterhaltung der Funktion.
Die Ursache ist nach wie vor multifaktoriell und umfasst genetische, umweltbedingte und altersbedingte Faktoren. Zu den Risikofaktoren gehören die Familienanamnese, die Exposition gegenüber Neurotoxinen und wiederholte Schädeltraumata. Präventionsstrategien konzentrieren sich auf den Schutz des Nervensystems durch regelmäßige Bewegung, eine gesunde Ernährung, die reich an Antioxidantien ist, die Vermeidung von Pestiziden und Kopfverletzungen sowie die Überwachung von Personen mit hohem Risiko. Frühzeitige Maßnahmen zur Änderung des Lebensstils können dazu beitragen, das Fortschreiten der Symptome zu verzögern.
Die Biologie dahinter
Das primäre Parkinson-Syndrom ohne oder mit minimaler Beeinträchtigung betrifft hauptsächlich die Basalganglien, eine Region im Gehirn, die für die Koordination willkürlicher Bewegungen, die Muskelkontrolle und das Gleichgewicht verantwortlich ist. Innerhalb der Basalganglien produziert die Substantia nigra Dopamin, einen Neurotransmitter, der für sanfte und kontrollierte Bewegungen unerlässlich ist. Dopamin ermöglicht eine effektive Kommunikation zwischen den Neuronen, reguliert die Motorik und verhindert unwillkürliche Muskelaktivität.
In den frühen Stadien der Parkinson-Krankheit kommt es zu einer allmählichen Verschlechterung der dopaminergen Neuronen in der Substantia nigra, was zu einer leichten Verringerung des Dopaminspiegels führt. Während die Symptome minimal sind, können subtile Bewegungsänderungen wie ein leichtes Zittern, ein reduzierter Armschwung oder eine leichte Steifheit auftreten. Das Gehirn gleicht den Dopaminverlust durch eine erhöhte Aktivität in anderen motorischen Bahnen aus und trägt so zur Aufrechterhaltung normaler Bewegungsabläufe bei.
Mit Fortschreiten der Krankheit nimmt der Dopaminmangel weiter zu und die Kompensation wird weniger wirksam. Obwohl die motorischen Symptome noch mild sind, können aufgrund der veränderten Neurotransmitterfunktion in anderen Hirnregionen bereits nicht-motorische Symptome wie Müdigkeit, Stimmungsschwankungen und Schlafstörungen auftreten.
Arten und Symptome
Das primäre Parkinson-Syndrom ohne oder mit minimaler Beeinträchtigung stellt das Frühstadium der Parkinson-Krankheit dar, in dem die Symptome mild sind und der Alltag weitgehend unbeeinträchtigt bleibt. Motorische Symptome können zwar auffällig sein, verursachen aber noch keine signifikante Behinderung. Es können jedoch auch frühe nicht-motorische Symptome auftreten, die manchmal den bewegungsbezogenen Anzeichen vorausgehen. Die Erkennung dieser frühen Symptome ist für eine rechtzeitige Diagnose und Behandlung unerlässlich.
Symptome:
Ruhetremor: Ein subtiler, rhythmischer Tremor tritt oft in einer Hand, einem Bein oder sogar im Kiefer auf, wenn man sich in Ruhe befindet. Der Tremor verschwindet bei willkürlichen Bewegungen und beeinträchtigt die täglichen Aufgaben möglicherweise nicht, ist aber oft das erste wahrnehmbare Anzeichen. Er beginnt in der Regel auf einer Seite und kann sich mit der Zeit langsam auf die andere Seite ausbreiten.
Bradykinesie (Bewegungsverlangsamung): Bei den Patienten kommt es zu einer allmählichen Verringerung der Bewegungsgeschwindigkeit. Einfache Aufgaben wie das Zuknöpfen eines Hemdes oder das Schreiben können länger dauern. Bewegungen können sich steif und weniger flüssig anfühlen, insbesondere morgens oder nach Ruhephasen.
Muskelsteifheit: Steifheit in den Armen, Beinen oder Nackenmuskeln kann zu Beschwerden führen und den Bewegungsumfang einschränken. Sie kann zu leichten Gelenkschmerzen und einem Gefühl der Muskelverspannung führen, insbesondere auf einer Körperseite.
Leichte Haltungsinstabilität: Das Gleichgewicht kann leicht beeinträchtigt sein, was zu leichten Schwierigkeiten beim Drehen oder beim Erhalt der Stabilität führen kann. Stürze sind in diesem Stadium jedoch selten.
Komplikationen:
Müdigkeit: Patienten können unerklärliche Müdigkeit oder einen Energiemangel verspüren, selbst wenn die Symptome nur leicht ausgeprägt sind.
Schlafstörungen: Leichte Schlaflosigkeit, unruhige Beine oder eine REM-Schlafverhaltensstörung können vor oder zusammen mit motorischen Symptomen auftreten.
Stimmungsschwankungen: Aufgrund subtiler Dopamin-Ungleichgewichte im Gehirn können frühe Angstzustände, Depressionen oder Apathie auftreten.
Obwohl die Symptome in diesem Stadium mild und beherrschbar sind, kann die Überwachung des Fortschreitens und die frühzeitige Einleitung von Maßnahmen dazu beitragen, eine Verschlechterung hinauszuzögern.
Untersuchung und Diagnose
Die Diagnose des primären Parkinson-Syndroms ohne oder mit minimaler Beeinträchtigung ist schwierig, da die frühen Symptome subtil sein können und sich mit anderen Erkrankungen überschneiden können. Es gibt keinen definitiven Test, sodass die Diagnose auf klinischer Bewertung, medizinischer Vorgeschichte und neurologischer Untersuchung beruht. Bildgebende Verfahren und Laboruntersuchungen werden in erster Linie eingesetzt, um andere Ursachen von Parkinsonismus auszuschließen, und nicht, um die Krankheit selbst zu bestätigen.
Klinische Untersuchung:
Eine gründliche Anamnese ist unerlässlich, um frühe Symptome und Risikofaktoren zu erkennen. Der Arzt wird nach folgenden Punkten fragen:
Motorische Symptome: Tremor, Steifheit, langsame Bewegungen.
Nicht-motorische Symptome: Schlafstörungen, Müdigkeit, Stimmungsschwankungen.
Familienanamnese: Vorliegen neurodegenerativer Erkrankungen bei nahen Verwandten.
Medikamenteneinnahme: Insbesondere Dopamin-blockierende Medikamente, die sekundären Parkinsonismus verursachen können.
Umweltexposition: Pestizide, Schwermetalle oder andere Neurotoxine.
Die neurologische Untersuchung konzentriert sich auf die Erkennung früher Anzeichen einer dopaminergen Dysfunktion. Zu den wichtigsten Untersuchungen gehören:
Ruhetremor-Bewertung: Beobachtung auf einseitiges Zittern von Hand, Bein oder Kinn, während der Patient sich in Ruhe befindet.
Bradykinesie-Test: Bewertung verlangsamter repetitiver Bewegungen, wie z. B. Fingertippen.
Erkennung von Muskelsteifheit: Überprüfung auf Widerstand gegen passive Bewegung der Gliedmaßen (Zahnradsteifigkeit).
Beurteilung der Haltungsinstabilität: Durchführung des Zugtests zur Beurteilung der Gleichgewichtsreflexe.
Es kann ein Levodopa-Provokationstest durchgeführt werden, bei dem dem Patienten dopaminerge Medikamente verabreicht werden, um zu sehen, ob sich die Symptome verbessern, was die Diagnose stützt.
Labortests und Bildgebung:
MRT- oder CT-Scan: Schließt Schlaganfall, Tumore oder strukturelle Hirnanomalien aus.
DaTscan (Dopamin-Transporter-Bildgebung): Beurteilt den Dopaminmangel in den Basalganglien und unterscheidet Parkinson von essentiellem Tremor.
Blutuntersuchungen: Werden verwendet, um Stoffwechsel- oder Autoimmunerkrankungen auszuschließen, die Parkinson imitieren, wie z. B. Schilddrüsenfunktionsstörungen oder Morbus Wilson.
Eine frühzeitige und genaue Diagnose ermöglicht rechtzeitige Interventionen, um das Fortschreiten der Krankheit zu verlangsamen und die langfristigen Ergebnisse zu verbessern.
Therapie und Behandlungen
Bei einem Parkinson-Syndrom im Frühstadium ohne oder mit minimalen Beeinträchtigungen liegt der Schwerpunkt auf der Symptombehandlung, der Verlangsamung des Fortschreitens der Krankheit und der Erhaltung der Lebensqualität. Da die Symptome mild sind, beginnt die Behandlung in der Regel mit nicht-pharmakologischen Maßnahmen, wodurch der Bedarf an Medikamenten so lange wie möglich hinausgezögert wird. Ein multidisziplinärer Ansatz, an dem Neurologen, Physiotherapeuten und Logopäden beteiligt sind, ist für die langfristige Behandlung unerlässlich.
Nicht-pharmakologische Therapie:
Bewegung und Physiotherapie: Regelmäßige Aerobic-Übungen, Krafttraining und Gleichgewichtsübungen verbessern die Motorik und verzögern das Fortschreiten der Symptome. Tai Chi und Yoga fördern die Beweglichkeit und reduzieren Steifheit.
Ergotherapie: Hilft Patienten, sich an subtile motorische Schwierigkeiten bei täglichen Aktivitäten wie Handschrift und feinmotorischen Aufgaben anzupassen.
Sprachtherapie: Empfohlen für Patienten mit leichten Sprach- oder Schluckbeschwerden.
Kognitive und psychologische Unterstützung: Frühzeitige Beratung, kognitive Therapie und psychische Betreuung helfen bei der Bewältigung potenzieller Stimmungsschwankungen.
Pharmakologische Behandlung:
Levodopa (L-DOPA) mit Carbidopa: Das wirksamste Medikament, wird jedoch oft erst eingesetzt, wenn die Symptome das tägliche Leben erheblich beeinträchtigen.
Dopaminagonisten (Pramipexol, Ropinirol): Werden bei jüngeren Patienten eingesetzt, um die frühe Abhängigkeit von Levodopa zu verringern.
MAO-B-Hemmer (Selegilin, Rasagilin): Können den Dopaminabbau verlangsamen und das Fortschreiten der Symptome verzögern.
Unterstützende Pflege und Lebensstiländerungen:
Ernährungsunterstützung: Eine Ernährung, die reich an Antioxidantien und Omega-3-Fettsäuren ist, kann die Gesundheit des Gehirns unterstützen.
Schlafmanagement: Die Behandlung von Schlaflosigkeit und REM-Schlafstörungen verbessert das allgemeine Wohlbefinden.
Chirurgische Eingriffe:
Eine tiefe Hirnstimulation (THS) wird in diesem Stadium nicht empfohlen, kann aber bei einem späteren Krankheitsverlauf in Betracht gezogen werden.
Eine frühzeitige Therapie und eine Änderung des Lebensstils können den Patienten dabei helfen, ihre Unabhängigkeit zu bewahren und weitere motorische Beeinträchtigungen hinauszuzögern.
Ursachen und Risikofaktoren
Für eine frühzeitige Erkennung und Behandlung ist es unerlässlich, die Ursachen und Risikofaktoren des primären Parkinson-Syndroms ohne oder mit nur minimalen Beeinträchtigungen zu verstehen. Die genaue Ursache ist zwar unbekannt, doch Forschungsergebnisse deuten darauf hin, dass eine Kombination aus genetischen, umweltbedingten und neurobiologischen Faktoren zu seiner Entwicklung beiträgt. Die Identifizierung von Risikofaktoren hilft bei der Beurteilung der Anfälligkeit und bei der Ausrichtung von Präventionsstrategien.
Ursachen:
Das primäre Parkinson-Syndrom entsteht durch die allmähliche Degeneration von Dopamin produzierenden Neuronen in der Substantia nigra, einer Region des Gehirns, die für die motorische Steuerung verantwortlich ist. Dies führt zu einem Dopaminmangel, der die Kommunikation zwischen den Basalganglien und dem motorischen Kortex stört. Der genaue Grund für diesen neuronalen Verlust ist unklar, aber zu den möglichen Mechanismen gehören oxidativer Stress, mitochondriale Dysfunktion, Proteinfehlfaltung (Alpha-Synuclein-Akkumulation) und chronische Neuroinflammation. Diese Prozesse beeinträchtigen allmählich die motorische Funktion und führen zu Symptomen im Frühstadium wie leichtem Zittern, Steifheit und Bradykinesie.
Risikofaktoren:
Alter: Der wichtigste Risikofaktor, wobei die Inzidenz nach dem 50. Lebensjahr aufgrund des natürlichen neuronalen Verlusts und der verringerten Dopaminproduktion zunimmt.
Genetik: Obwohl die meisten Fälle sporadisch auftreten, können Mutationen in Genen wie LRRK2, PARK7, PINK1 und SNCA die Anfälligkeit erhöhen.
Umweltexposition: Pestizide, Schwermetalle und Luftschadstoffe können zu neuronalen Schäden und zum Ausbruch der Krankheit beitragen.
Kopftrauma: Wiederholte Kopfverletzungen durch Kontaktsportarten oder Unfälle können die Neuroinflammation und Proteinaggregation verstärken und das Risiko erhöhen.
Geschlecht: Männer haben ein etwas höheres Risiko als Frauen, was möglicherweise auf hormonelle Unterschiede und Lebensstilfaktoren zurückzuführen ist.
Diese Risikofaktoren tragen zwar zur Entwicklung der Parkinson-Krankheit bei, aber nicht jeder, der diese Faktoren aufweist, erkrankt auch daran, und einige Personen ohne Risikofaktoren können dennoch betroffen sein. In der laufenden Forschung werden weiterhin zusätzliche Ursachen und Schutzfaktoren untersucht.
Krankheitsverlauf und Prognose
Das primäre Parkinson-Syndrom ohne oder mit minimaler Beeinträchtigung stellt das früheste Stadium der Parkinson-Krankheit dar, in dem die Symptome mild sind und das tägliche Leben möglicherweise noch nicht beeinträchtigen. Da es sich bei Parkinson jedoch um eine fortschreitende neurodegenerative Erkrankung handelt, verschlechtern sich die Symptome mit der Zeit allmählich. Das Verständnis des Krankheitsverlaufs und der Prognose hilft dabei, die Erwartungen zu steuern und die Langzeitpflege zu planen.
Krankheitsverlauf:
Im Frühstadium, das den Stadien 0 bis unter 3 nach Hoehn und Yahr entspricht, entwickeln sich die Symptome allmählich und betreffen oft zuerst eine Körperseite. Die Patienten können ein leichtes Ruhezittern, eine leichte Steifheit und eine subtile Bradykinesie (verlangsamte Bewegungen) verspüren. Mit fortschreitender Krankheit werden die Symptome beidseitig und können Haltungsinstabilität und Schwierigkeiten bei feinmotorischen Aufgaben umfassen.
Der zeitliche Verlauf der Krankheit ist von Person zu Person sehr unterschiedlich. Bei einigen Patienten bleibt die Krankheit jahrelang in einem milden Stadium, während bei anderen die Symptome schneller fortschreiten. In der Regel treten bei den Patienten innerhalb von 5 bis 10 Jahren moderate Stadien auf, die eine Anpassung des Lebensstils erfordern. Ohne Behandlung kann die Krankheit innerhalb von 10 bis 20 Jahren zu schwereren Stadien (Hoehn und Yahr 4–5) fortschreiten, die zu einer erheblichen Behinderung führen.
Prognose:
Die Parkinson-Krankheit selbst ist zwar nicht tödlich, aber Komplikationen wie Stürze, Aspirationspneumonie und kardiovaskuläre Dysfunktion können die Lebenserwartung verkürzen. Studien deuten darauf hin, dass die Lebenserwartung um 1–3 Jahre reduziert sein kann, aber viele Patienten können bei angemessener Behandlung über Jahrzehnte hinweg ein aktives Leben führen.
Jüngere Patienten und Patienten mit milderen Symptomen bei der Diagnose neigen dazu, einen langsameren Krankheitsverlauf zu haben, während Personen mit frühen kognitiven Beeinträchtigungen oder schweren motorischen Symptomen schneller abbauen können. Obwohl Parkinson nicht rückgängig gemacht werden kann, können eine frühzeitige Intervention und eine konsequente Symptombehandlung die langfristige Lebensqualität verbessern und eine erhebliche Behinderung hinauszögern.
Prävention
Es gibt zwar keine garantierte Möglichkeit, das primäre Parkinson-Syndrom zu verhindern, doch Forschungsergebnisse deuten darauf hin, dass bestimmte Änderungen des Lebensstils und Strategien zur Risikominderung dazu beitragen können, den Ausbruch der Krankheit zu verzögern oder die Wahrscheinlichkeit, an ihr zu erkranken, zu verringern. Da Parkinson durch eine Kombination aus genetischen, umweltbedingten und neurobiologischen Faktoren verursacht wird, konzentriert sich die Prävention auf die Reduzierung bekannter Risikofaktoren und die Förderung der Gehirngesundheit.
Regelmäßige körperliche Aktivität:
Studien deuten darauf hin, dass regelmäßige Bewegung dazu beitragen kann, das Risiko einer Parkinson-Erkrankung zu verringern, indem sie die Dopaminregulation, die Neuroplastizität und die motorische Funktion verbessert. Aktivitäten wie Aerobic, Krafttraining, Yoga und Tai Chi verbessern das Gleichgewicht, die Koordination und die Muskelkraft und können so das Fortschreiten der Krankheit verlangsamen.
Gesunde Ernährung und Antioxidantien:
Eine Ernährung, die reich an Antioxidantien, Omega-3-Fettsäuren und entzündungshemmenden Lebensmitteln ist, unterstützt die Gesundheit des Gehirns. Die mediterrane Ernährung, die Obst, Gemüse, Vollkornprodukte, Nüsse und gesunde Fette umfasst, wird mit einem geringeren Risiko für neurodegenerative Erkrankungen in Verbindung gebracht. Auch der Verzicht auf verarbeitete Lebensmittel, übermäßigen Milchkonsum und zuckerreiche Ernährung kann von Vorteil sein.
Vermeidung neurotoxischer Exposition:
Pestizide, Herbizide, Schwermetalle und Luftschadstoffe wurden mit einem erhöhten Parkinson-Risiko in Verbindung gebracht. Die Reduzierung der Exposition durch die Verwendung von Schutzausrüstung, den Verzehr von Bio-Lebensmitteln und die Vermeidung von Industriegiften kann dazu beitragen, das Risiko zu senken.
Schutz vor Kopfverletzungen:
Kopftrauma ist ein möglicher Risikofaktor für Parkinson. Das Tragen von Helmen beim Sport, das Anlegen von Sicherheitsgurten und die Vermeidung von Stürzen können die Wahrscheinlichkeit von Hirnverletzungen verringern, die zur Neurodegeneration beitragen können.
Überwachung des genetischen Risikos:
Personen, in deren Familie Parkinsonfälle bekannt sind, können von einer genetischen Beratung und frühzeitigen Vorsorgeuntersuchungen profitieren. Obwohl Gentests nicht weit verbreitet sind, können Personen mit bekannten Mutationen schützende Lebensstilstrategien anwenden, um den Ausbruch möglicherweise zu verzögern.
Zusammenfassung
Das primäre Parkinson-Syndrom ohne oder mit minimaler Beeinträchtigung ist das früheste Stadium der Parkinson-Krankheit, bei dem die Symptome mild bleiben und die täglichen Aktivitäten weitgehend unbeeinflusst bleiben. Zu den Symptomen gehören Ruhetremor, Bradykinesie, Muskelsteifheit und leichte Haltungsinstabilität, die oft einseitig auftreten und mit der Zeit fortschreiten. Die Diagnose stützt sich auf klinische Beurteilung und Bildgebung, während die Behandlung auf Bewegung, Physiotherapie und die Verschreibung von Medikamenten erst bei Bedarf ausgerichtet ist. Obwohl Parkinson nicht tödlich ist, schreitet die Krankheit fort, wobei die Schwere der Symptome über einen Zeitraum von 5 bis 20 Jahren zunimmt. Zu den Risikofaktoren gehören Alter, Genetik, Umwelteinflüsse und Schädeltrauma. Es gibt zwar keine bekannte Prävention, aber die Aufrechterhaltung eines aktiven Lebensstils, eine gehirngesunde Ernährung und die Minimierung der Toxinexposition können dazu beitragen, das Risiko, an Parkinson zu erkranken, zu verringern. Eine frühzeitige Intervention verbessert die langfristigen Ergebnisse erheblich.